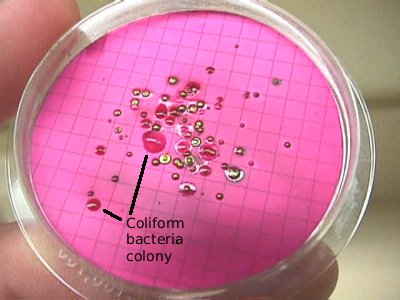

Trong phần này, chúng ta sẽ tìm hiểu những điều sau đây:
• Sự khác nhau giữa các tế bào procaryotic và eucaryotic ?
• Đâu là những tế bào eucaryotic tìm thấy trong môi trường?
-----------------------------------------------
dem vi sinh lamela
Một lượng lớn các vi khuẩn có thể gây bệnh qua đường nước. Ở đây, chúng ta sẽ xem xét một vài trong số những loài phổ biến như sau:
- Campylobacter,
- Escherichia coli,
- Salmonella,
- Shigella, và
- Vibrio cholerae.
-----------------------------------------
dem vi sinh lamela
Phân loại
Có hàng ngàn loài vi khuẩn trên trái đất, rất nhiều trong số đó chưa được xác định. Để phân loại khuẩn, các nhà khoa học đã căn cứ đặc tính thị giác và kiểm tra trong phòng thí nghiệm.
Di chuyển thụ động
Di chuyển thụ động các chất vào và ra khỏi tế bào tương tự như một cuộn đá xuống dốc. Có ba loại di chuyển thụ động:
---------------------------------
dem vi sinh lamela
Mục tiêu
Trong bài này, chúng ta sẽ tìm hiểu các khái niệm sau đây:
• Cấu trúc của vi khuẩn.
• Các giai đoạn tăng trưởng của vi khuẩn.
• Các loại hô hấp.
• Làm thế nào để xác định và phân loại vi khuẩn.
---------------------------------------
Dem vi sinh lamela
Virus là những sinh vật sinh sản trong tế bào sống. Như vậy, tất cả các virus là ký sinh và gây ra một số loại bệnh. Viêm gan truyền nhiễm, bệnh bại liệt, cúm, đậu mùa, bệnh AIDS, và một loạt các rối loạn đường ruột đều là do virus.
---------------------------------------
dem vi sinh lamela
Ngoài các vi sinh vật đề cập ở trên, một vài sinh vật đa bào rất quan trọng trong nước và xử lý nước thải. Trong phần này, chúng ta sẽ xem xét hai loại sinh vật đa bào quan trọng - luân trùng và sâu.
--------------------------------------
dem vi sinh lamela
Động vật nguyên sinh là sinh vật đơn bào, dị dưỡng và lưu động tại một số giai đoạn trong cuộc sống của chúng. Chúng không có một bức tường tế bào, mặc dù màng của họ thường được bao quanh bởi một màng mỏng (một, linh hoạt, lớp phủ bảo vệ mỏng).
---------------------------------------------------
dem vi sinh lamela
Tác giả muốn giới thiệu với độc giả một chủ đề được gọi là nước và xử lý nước. Trong nước và nước thải, có rất nhiều khái niệm để tìm hiểu vì vậy tác giả nghĩ rằng, chúng ta sẽ bắt đầu với cách xử lý nước tự nhiên - chu kỳ thủy văn học.
Tảo có thể là đơn bào (trong trường hợp đó chúng được gọi là thực vật phù du) hoặc đa bào. Loại tảo rất quan trọng để xử lý nước là tảo đơn bào. Tảo có thể không di chuyển được, nhưng chúng có thể di chuyển bằng cách sử dụng một roi, trong trường hợp đó họ được gọi là flagellates (một thuật ngữ dựa trên hình thái chứ không phải là cách phân loại).
-----------------------------------------
dem vi sinh lamela
Vì có rất nhiều loại khác nhau của sinh vật nhân chuẩn, một số thành phần thể hiện như trên sẽ không có mặt ở một số loài. Ngoài ra, một số loài có chứa các thành phận bổ sung nhưng không được thể hiển ở trên.
-----------------------------------------
dem vi sinh lamela
Phân loại vi sinh là sự sắp xếp các sinh vật thành các nhóm liên quan. Trong bài này, chúng ta sẽ giải thích các loại vi sinh vật bao gồm vi khuẩn, tảo, nấm, động vật nguyên sinh và vi rút. Ngoài ra, chúng ta sẽ xem xét ngắn gọn một vài sinh vật lớn hơn như luân trùng và sâu. Nhưng trước khi chúng ta xem xét các loại khác nhau của vi sinh vật, bạn cần phải hiểu làm thế nào các nhà khoa học phân loại tất cả các sinh vật sống.
---------------------------------------
dem vi sinh lamela
Vấn đề phổ biến nhất liên quan đến nguồn nước ngầm là độ cứng, nó thường gắn liền với một sự dồi dào canxi và / hoặc magiê hòa tan trong nước. Nước cứng chưa được chứng minh là gây ra vấn đề cho sức khỏe, nhưng có thể là một mối phiền toái vì nó có thể gây ra đóng cục trên các đường ống và đường ống nước khác. Qua thời gian, điều này có thể làm giảm đường kính của đường ống.
-------------------------------
dem vi sinh lamela
Nước ngầm được coi là một loại khoáng chất trong thiên nhiên, vì vậy nó có thể được khai thác bởi những người sở hữu đất ở trên nó. Nước ngầm được chiết xuất từ các lớp bão hòa hoặc thông qua suối hoặc giếng. Suối là khu vực mà mực nước ngầm thoát lên trên bề mặt của trái đất, và chảy thành dòng trên mặt đất.
------------------------------------
dem vi sinh lamela